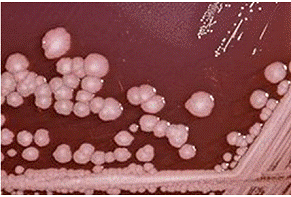

|
Дата
|
Автор
|
Подія
|
|
1885
|
Хаузер
|
Описав
рід Proteus та види P. mirabilis, P. vulgaris, P. zenkeri
|
|
1919
|
Веннер
, Ретгер
|
Розділили
види P. mirabilis, P. vulgaris на основі ферментативних властивостей
|
|
1966
|
Козенц
та Подгвайт
|
Описали
P.myxofaciens
|
|
1978
|
Бреннер
|
Визначив
біогрупи P.vulgaris
|
|
1982
|
Хікман
|
Описав
P. penneri; створив дві додаткові біогрупи з P.vulgaris
|
У 1894 році Теобальд Сміт дослідив ферментативні
характеристики двох видів , використовуючи глюкозу, сахарозу і лактозу. Через
рік, Хаузер продемонстрував дослідження про незвичайно малу кількість газу,
одержаного з глюкози Р.vulgaris в порівнянні з іншими, відомими до того
кишковими мікроорганізмами.
У 1919 році Г. Веннер і Б. Ретгер в Коннектикуті вивчали
біохімічні характеристики великої групи штамів роду Proteus. Відповідно з
відкриттями Хаузера 1885 року, їх штами також роїлися і розріджували желатин.
Всі ці штами також виділяли сірководень і не мали ферментів для розщеплення
лактози. Здатність ферментувати глюкозу, сахарозу, мальтозу і далі служила
засобом розділяти штами на дві групи, як це було зроблено Хаузером. Р.vulgaris
ферментує глюкозу, сахарозу і мальтозу легко, коли P.mirabilis зброджує глюкозу
і сахарозу повільно і не зброджує мальтозу зовсім.
У 1966, В.Козенц і Ф. Подгвайт описали новий вид , Proteus
myxofaciens, що був виділений з личинок непарного шовкопряда [3].може
відображати дві різні морфологічні і фізіологічні форми; одна відома як клітина-плавець,а інша як членистонога клітина.
В водній суспензії P.mirabilis знаходиться в стані клітини-плавця. Це невелика
паличкоподібна клітина 1-2 мкм в довжину. Вона містить від 8 до 10 джгутиків,
які допомагають їй у плавальній моториці. При контакті з поверхнею, Proteus
mirabilis переходить у стан членистоногої клітини, де клітина значно збільшує
довжину з утворенням довгих джгутикових ниток від 20 до 80 мкм в довжину. Ці
клітини шикуються паралельно, утворюючи плоти, які здатні швидко переміщуватися
по поверхні в масовому порядку. На твердих поверхнях, таких як агарова
поверхня, вони утворюють концентричні кільця зростання. Ця картина викликана
скоординованим роїнням бактерій. Як і інші грамнегативні бактерії, Proteus
mirabilis має цитоплазматичну зовнішню мембрану. Крім того, зовнішня оболонка
містить ліпідний бішар, ліпопротеїни, полісахариди, ліпополісахариди та інші
компоненти мембрани, що визначають його вірулентність [4].
Рис.1.2. Proteus mirabilis 24 годинна культура на кров’яному
агарі (формування частин його концентричничних кілець)
Явище роїння є особливістю Proteus mirabilis, як і деяких
інших бактерій роду Proteus, якому сприяє перитрихіальне розташування
джгутиків, яке є швидким і скоординованим переміщенням бактеріальної популяції
на твердих або напівтвердих поверхнях. Ця здатність допомагає їм у здобуванні
їжі, розмноженні і рості. Це також допомагає бактерії у вираженні своїх
факторів вірулентності і вторгнення в уротеліальні клітини господарів. Уротелій
(перехідний епітелій) покриває шляхи сечостатевого виділення. Вистилає ниркові
миски, сечоводи, сечовий міхур і проксимальну частину уретри. Залежно від
локалізації має товщину в 5-8 шарів клітин. При хронічному запаленні і
пухлинному рості він здатний до плоскоклітинної або залозистої метаплазії [5].
1.2 Фізіолого-біохімічні ознаки
Протеї ростуть на простих середовищах в широкому
діапазоні температур. Оптимальна рН - 7,2-7,4 , температура - від +35 до +370С.
Рис.1.3. Культура Proteus mirabilis на агаризованому
поживному середовищі
Колонії протеїв в О-формі округлі,
напівпрозорі опуклі, Н- форми дають суцільний ріст. Зростання протеїв
супроводжується гнильним запахом.
Рис.1.4.Proteus mirabilis на кров’яному агарі (зріла
культура)
Характерне роїння, Н- форми (мають
Н-антигени) дають на МПА - характерний повзучий ріст у вигляді
блакитно-димчастої ніжною вуалі. При посіві за методом Шушкевича в
конденсаційну вологу свіжоскошеного МПА культура поступово піднімається у
вигляді вуалі вгору по поверхні агару. На МПБ (м’ясо-пептонному бульйоні)
відзначають дифузне помутніння середовища з густим білим осадом на дні. На
середовищі Плоскірєва формують блискучі прозорі жовтувато - рожеві колонії (з
підлуджням і пожовтінням середовища навколо колоній). В якості середовищ
збагачення використовують середовища Мюллера, Кауфмана, 5% жовчний бульйон. Як і у інших
ентеробактерій, у протеїв маються О-, Н-і К-антигени. Соматичні О-антигени
термостабільні, жгутикові Н-антигени термолабільні. Для серологічної
ідентифікації визначають структуру О-і Н-антигенів. У протеїв мається антигенна
спорідненість з рикетсіями. Цю їх властивість раніше застосовували для серологічної
діагностики рикетсіозів. Rickettsia - рід нерухомих, грамнегативних,
неспороутворючих, надзвичайно плеоморфних бактерій, що можуть мати форму коків,
паличок. Rickettsia- облігатні внутрішньоклітинні паразити, тобто залежать від
находження в межах цитоплазми еукаріотичних клітин-хазяїв(зазвичай
епітеліальних клітин).
При вирощуванні на 1,5%-ому м'ясо-пептонному агарі, що
містить 50 еритроцитів кролика, при 35-360C штам дає на поверхні
поживного середовища характерний ріст у вигляді вуалі із зоною гемолізу. При
вирощуванні в бульйоні Хоттингера (pH 7,2-7,4), температура 35 - 360C
, протягом 20 годин дає дифузне помутніння і ніжну плівку на поверхні
середовища [6].
Індолнегативні штами P.mirabilis, як правило, більш чутливі
до протимікробних препаратів, ніж Р.vulgaris, P.penneri, і P.hauseri. Але
P.mirabilis має внутрішню стійкість до тетрацикліну і нітрофурантоїну, але
зазвичай сприйнятливі до аміно- і уреідо - пеніцилінів (ампіцилін, амоксицилін,
і піперацилін), цефалоспоринів (цефазолін, цефокситин, цефуроксим, цефотаксим,
цефоперазон, цефтріаксон, цефепім), аміноглікозидів (амікацин, гентаміцин і
тобраміцину), іміпенему, ципрофлоксацину і триметоприм-сульфаметоксазолу.
Проте, випадки високого рівня опору ципрофлоксацину були зареєстровані для P.mirabilis
в дослідах, де використання цього агента не обмежено. Внутрішній опір до
тетрацикліну може бути використаний в якості маркера для ідентифікації даного
організму [7].
Геном Proteus mirabilis має вміст G+C 38,88%. Існує єдиний
плазмід, що складається з 36 289 нуклеотидів. Геном ідентифікується 3685
кодуючими послідовностями і сімома рРНК локусами. Його геном був повністю
секвенований. Дослідник проблеми каменеутворення у сечовідних шляхах Джон
Пірсон зазначив: "Частина нашої мети - пошук потенційних цілей для нових
вакцин , які могли б захистити людей від інфекції". "У випадках, коли
бактерії утворюють каміння, вони можуть бути стійкими до антибіотиків" ,
говорить Гаррі Моблі, доктор філософії , професор і голова мікробіології та імунології
в Медичному Інституті UM. Моблі є експертом з уреази. Дослідження Пірсона
пояснює, чому бактерія має можливість триматися деяких поверхонь.
"P.mirabilis має незвично велику кількість генів , які кодують 15 різних
факторів слідування або фімбрії на його поверхні" , пояснює Пірсон.
"Всі ці різноманітні фімбрії допомогають бактерії триматися клітин
сечового міхура, катетерів, каменів в нирках або один одного."
Пірсон також виявив, що геном Proteus mirabilis складається з
24 генів, які кодують компоненти системи,що використовується для введення
бактеріальних білків в клітини-господарі. У дослідженні, Пірсон використовує
генні мікромасиви, щоб ідентифікувати гени Proteus mirabilis, які включені чи
виражені, на стадії інфекції. Гени, залучені в процесі інфекції є головними
цілями для майбутнього розвитку вакцини.
1.3 Екологія та поширення Proteus mirabilis
Протеї є мешканцями
кишечника людини і багатьох тварин, вологої поверхні агару. Proteus mirabilis
також знаходили у стічних водах,у водоймах, на овочах. Є представниками нормальної мікрофлори людини. У
навколишньому середовищі вони більш стійкі, ніж ешерихії, і навіть здатні
зберігати життєдіяльності в слабких розчинах фенолу та інших дезінфектантів. Ці
мікроорганізми - сапрофіти. Виділяючись від хворих,
мікроорганізми довгий час зберігаються на предметах побуту, медичних
інструментах. Чутливі до змін температури, оптимальна для них 35-370С.
У природі протеї поширені широко, беруть участь у процесах гниття,
розмножуючись в органічних субстратах.
Протеї ростуть на простих
середовищах в широкому діапазоні температур. Proteus mirabilis вільно живуть у
вологих місця, таких як вода і грунт. Вони також знайдені в гнилому м'ясі,
навозі і абсцесах. Proteus mirabilis потребує середовища, що має високу
лужність, це означає, що концентрація лугу в розчині, який вимірюється з точки
зору рН , повинна бути високою. Підходяще середовище для Proteus mirabilis
повинне мати рН вище 7. Proteus mirabilis колонізує сечовивідні шляхи,
розщеплюючи сечовину до гідроксиду аміаку і цим олужує сечу та утворює каміння.
Це каміння заважає відтоку сечі, слугує постійним джерелом інфекції і руйнує
ниркову паренхіму. Це призводить до підвищення рівня рН сечового міхура а,
отже, й до інфекції сечових шляхів [8].
Розділ ІІ. Значення бактерій Proteus mirabilis
2.1 Патогенність Proteus mirabilis
Proteus mirabilis викликає 90% інфекцій людини з роду
Proteus. Це в першу чергу в сечових шляхах. Протеї виділяють токсичні речовини
- ендотоксини з гемолітичними властивостями і з різним ступенем біохімічної
активності.
Патогенність P.mirabilis здійснюється в наступні два кроки.
По-перше, мікроорганізм повинен колонізувати сечовивідні шляхи і, по-друге,
мікроорганізм повинен успішно ухилитися від захисних сил організму. Бактерія
також виробляє уреазу. Уреаза (від грец ούρον
- сеча і
"-аза" - стандартний афікс біохімічної номенклатури, який вказує на
приналежність речовини до класу ферментів) - гідролітичний фермент з групи
амидаз, що володіє специфічною властивістю каталізувати гідроліз сечовини до
діоксиду вуглецю та аміаку. Крім того , гемолізини, що виділяє бактерія,
цитотоксичні для сечових шляхів епітеліальних клітин , які підлягають
вторгненню Proteus mirabilis. Роїння бактерії також відіграє важливу роль в
ниркових інфекціях , що включає колонізацію нижніх сечових шляхів і потім
висхідний рух бактерії. Вважається, що роїння корелює з ефективним вторгненням
в епітелії клітин господарів, так як воно забезпечує здатність швидко рухатися
і, отже, швидко колонізувати і проникати в клітини [9].
Фімбрії (з лат. fimbriac -
бахрома), довгі, тонкі, прямі вирости, що складаються з гідрофобного білка і
знаходяться у великій кількості (інколи до декількох тисяч) на поверхні кліток
грамнегативних бактерій. Довжина фімбрій - до 12 мкм, товщина - не більше 0,2
мкм. Вони значно тонші і коротші за джгутики. "Чоловічі" клітини
бактерій (донори) можуть мати 1-3 статеві фімбрії (пілі), створюючі між ними і
"жіночими" клітками (реципієнтами) порожнисті містки, через які при
кон’югації бактерій передається ДНК(дезоксирибонуклеїнова кислота). Фімбрії
можуть бути як у рухливих, так і в нерухомих бактерій; виникають зазвичай з
базального тельця,що знаходиться в цитоплазматичній мембрані, і проходять через
клітинну стінку назовні. Фімбрії додають бактеріальній клітині неспецифічну
здатність "прилипати" до щільної поверхні клітин, тканин [10].
Є чотири етапи, за допомогою яких P.mirabilis ухиляється від
захисних сил організму. Перший - це виробництво IgA- принигнічуючої протеази ,
яка функціонує для розщеплення секреторної IgA . IgA звільняється
господарем-організмом у початковій відповідь на інфекцію. Другий імунний
механізм ухилення: система через три унікальні гени флажеліну, які задіяні для
рекомбінації і утворюють нові джгутики, здатні обманювати оборону господаря. Третій - експресії MRP-фімбрій. Вони проходять через процес
, що називається зміна фази , за якими вид джгутиків знайдений в деяких
клітинах змінюється. Четвертий - є формування каменів уреазою. Виробництво
аміаку під дією уреази призводить до кам'яного утворення, і ці камені у свою
чергу, захищають бактерії.
Уреаза і гемолізина як відомо, викликають пошкодження
епітеліальних клітин. Як згадувалося вище, уреаза може пошкодити епітеліальні
клітини господаря через утворення каменів. Гемолізина пошкоджує клітину через
її властивості як потужного цитотоксину.
При бактеріологічному дослідженні раньової поверхні
встановлено наявність полівалентної мікрофлори. Найчастіше висівались
комбінації Staphylococcus aureus, стрептококки Streptococcus pyogenes,
Haemophilus influenzae. У хворих на цукровий діабет - Escherichia coli, Proteus
mirabilis, Acinetobacter spp., Enterobacter spp. та Pseudomonas aeruginosa.Тому Proteus часто є причиною бактеріального вторгнення в
кровотік часто асоціюється з діабетом, хвороби серця і легенів, або рак через
експресії PMF-фімбрій [11].
.2 Практичне значення
Антигени, знайдені на зовнішній мембрані P.mirabilis потенційно
можуть служити як мішень для вакцин. Досі, з 37 виявлених імуно-реактивних
антигенів, 23 є поверхнево-пов'язані білки. Дослідження показали, що 2 білки
приєднання заліза (PMI0842 і PMI2596) збільшують вірулентність P.mirabilis в
сечових шляхах. Оскільки обидва цих білки сприяють патогенезу, вони найбільш
зручними мішенями для вакцин. Після того, як ефективна вакцина буде зроблена
для цих антигенів, подальші дослідження будуть визначати , чи може бути
використаний ці вакцини проти інших бактерій , які викликають складні інфекції
сечовивідних шляхів, таких як Providencia і Morganella.
Штам Proteus mirabilis 2536 виділений від хворого з
урологічної інфекцією в 1992 р., депонований в колекції Державного науково -
дослідного інституту стандартизації та контролю медичних біологічних препаратів
ім. Л. А. Тарасевича і має реєстраційний номер 237 . Генетичні особливості
штаму : стійкий до пеніциліну, неоміцину, мономіцину, поліміксину,
тетрацикліну, лінкоміцину, еритроміцину, ристоміцину, оксацилину, левоміцетину.
Штам має підвищену токсинопродукуючу здатність.
Винахід відноситься до біотехнології і може бути використано
для отримання термолабільного ентеротоксину (ЛТ- ентеротоксину і анатоксину
Proteus mirabilis при виробництві вакцин).
Термолабільні ентеротоксини активізують
клітинну аденілатциклазу, що призводить до порушення ентеросорбції та розвитку
діарейного синдрому. Такі токсини також продукують холерний вібріон (холероген)
та інші ентеротоксигенні кишкові палички
Метою винаходу є штам Proteus mirabilis 2536, що володіє
підвищеною токсинопродукуючою здатністю.
Штам Proteus mirabilis ГИСК N 237 характеризується наступними
ознаками:
Утворює фенілаланіндезаменозу, що не ферментує лактозу і
ферментує з утворенням кислоту і газу глюкозу , ксилозу , салицин , мальтозу ,
сахарозу , розщеплює сечовину , не продукує орітіндекарбоксілазу.
Способи визначення активності ЛТ- ентеротоксину :
Субплантарне введення мишам вагою 15-16 г 0,05 центрифугата
20 - 40 -годинної бульйонної культури викликає набряк лапки не менше 110 мг);
Інтраназальне введення 0,05 мг 20-40 годинної бульонної
культури викликає загибель 95 % мишей-самців вагою 15-16 г протягом 20 хвилин
при явищах тонічних судом і асфіксії;
Внутрішньом'язове введення 300 мл мікробних клітин до 20
-годинної бульонної культури викликає некроз шкіри кролика діаметром більше 3,5
см;
В досліді петля тонкої кишки кролика при введенні 500 млн
м.т. 20 -годинний бульонної культури дає позитивний результат;
Грітий при 560C протягом 45 хвилин центрифугат 20
-годинної бульйонної культури викликає " набряк лапки" мишей до 30 мг
,але не викликає некрозів шкіри кролика. Гріта при 100̊C 20 - годинна бульйонна
культура не викликає накопичення рідини в ізольованій петлі тонкого кишечника
кролика (v / l 0,3 /).
Умови зберігання культури після леофільного сушіння,вирощеній
на 0,3%-вому МПА (pH 7,2-7,4): залити стерильним вазеліновим маслом , при 40̊C .
Середовища для розмноження - бульйон Хоттенгера (pH 7,2-7,4),
що містить 5% еритроцитів кролика при температурі 35-360C протягом
20 годин.
2.3 Сучасні дослідження
Сучасні дослідження показують, що існує цілий ряд
антибіотиків, що колись були ефективні проти P.mirabilis, але тепер марні через
розширеного спектру бета лактамаз ( ESBLs ). Це ферменти, що пройшли через
плазміди і знаходяться в більшості ентеробактерій. Ці плазміди були знайдені в
абсцесах, крові, легких, перитонеальній рідині. Виявлені в 1980-х роках в
Klebsiella і E.coli, ці ферменти були виявлені для гідролізу антибіотика
цефалоспорина, що тепер є неефективним. ESBL'S стає дуже небезпечним, коли
вводиться великими кількостями, передаючи стійкість до великого числа
антибіотиків, які використовуються повсюдно. Поширення цих плазмід в першу
чергу відбувається в медичних установах, де пацієнти, які госпіталізовані,
використовують катетери після недавньої операції або вживають антибіотики.
Також було встановлено, що багато штамів Proteus
mirabilis виділяють токсичні білки-протіцини, призначені для боротьби з
конкуруючими штамами. Кожен штам виділяє свій протіцин, до якого він стійкий, і
до того ж має стійкість до деяких (але не до всіх ) чужим протіцинів. Однак
утворення кордонів між неспорідненими зграями визначається не протіцинами, а
чимось іншим. Справа в том , що деякі штами не виділяють протіцинів, але при
цьому все одно утворюють кордон, в тому числі і з іншими штамами, позбавленими
протіцинів. Учені вважають, що ця генетична система розпізнавання чужаків
повинна перешкоджати "перенаселенню" середовища, де вони
розмножуються [12].
Висновки
. P.mirabilis - грамнегативні, паличкоподібні бактерії, які
можуть бути знайдені в кишечнику людини як частина мікрофлори. Вони в основному є жителями сечових шляхів людини. Цей
організм , як правило, непатогений, але стає проблемою, коли він вступає в
контакт з сечовиною у сечовивідних шляхах.
. Явище роїння є особливістю Proteus mirabilis, як і деяких
інших бактерій роду Proteus, якому сприяє перитрихіальне розташування джгутиків
, яке є швидким і скоординованим переміщенням бактеріальної популяції на
твердих або напівтвердих поверхнях
. Виробляє уреазу. Уреаза і
гемолізина як відомо , викликають пошкодження епітеліальних клітин.
Уреаза пошкоджує епітеліальні клітини господаря через утворення каменів .
Гемолізина пошкоджує клітину через її властивості як потужного цитотоксину.
. Антигени , знайдені на зовнішній мембрані P. Mirabilis
потенційно можуть використовуватися як мішень для вакцин не тільки роду
Proteus, а ще й таких родів як Providencia і Morganella.
. Штам Proteus mirabilis 2536 використовується для отримання
термолабільного ентеротоксину ( ЛТ-ентеротоксину і анатоксину Proteus mirabilis
) при виробництві вакцин проти інфекцій викликаних бактеріями таких родів як
Proteus, Providencia та Morganella, наприклад, колібактеріозу сільськогосподарських тварин.
Список використаної літератури
бактерія proteus mirabilis сечостатевий
1. Біотехнологія: Підручник / В.Г. Герасименко, М.О. Герасименко,
М.І. Цвіліховський та ін.; Під заг. ред. В.Г. Герасименка. - К.: Фірма
"ІНКОС", 2006. - 647 с.
2. Dumanski A.J.,
Hedelin H., Edin-Liljegren A., Beauchemin D. Unique
ability of the Proteus mirabilis capsule to enhance mineral growth in
infectious urinary calculi // Infection and immunity.-1994. - I. 62, V.7. -
P.2998-3003.
3. Allison C, Coleman N, Jones PL, Hughes C.
Ability of Proteus mirabilis to invade human urothelial cells is coupled to
motility and swarming differentiation.Infect Immun.- 1992.- І.11. V.26 -
P.4740-4746.
4. Allison C, Lai
H.C, Hughes C. Cordinate expression of virulence genes during swarm-cell
differentiation and population migration of Proteus mirabilis.//
Mol.Microbiol.-1992. - І.6.V.12- P. 1583-1591/
. Галапнонов В.Т.
Иммунология: Учебник. - М.: Издательство МГУ. 1998 - 480 с.
6. Бактерии в ЖКТ: нормальная микрофлора и
возбудители болезней- Режим доступа - http://www.gastroscan.ru/handbook/118/3344
7. Баранов А.Г., Галушко Н.В. Изучение влияния возможности
совместного применения биопрепаратов для уменьшения вредных последствий
распространения непарного шелкопряда // Культура народов Причерноморья. - 2012.
- №232. - С. 152-154
. Ромаев С.Н., Свириденко Л.Ю. Сравнительный анализ бактериального
пейзажа полости носа у больных гнойным верхнечелюстным синуситом //
Международный медицинский журнал. - 2006. - Т. 12, №1. - С. 37-40.
. Пиневич А.В., Сироткин А.К., Гаврилова О.В., Потехин А.А.
Вирусология: учебник. СПб.: Изд-во С.-Петерб. ун-та, 2012. - 432 с.
. Климнюк С.І., Ситник І.О., Творко М.С., Широбоков В.П. Практична
мікробіологія: Посібник. - Тернопіль: Укрмедкнига,2004,- 440 с.
11. Proteus
mirabilis - Access-http://en.citizendium.org/wiki/Proteus_mirabilis
. Gibbs K.A.,
Urbanowski M.L., Greenberg E.P. Genetic Determinahts of self identity and
social recognition in Bacteria // Scince. - 2008.-V.321.- P.256 - 259.